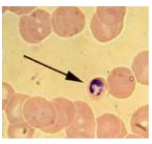
term image

1/23
Looks like no tags are added yet.
Name | Mastery | Learn | Test | Matching | Spaced | Call with Kai |
|---|
No study sessions yet.

sycon

leucosolenia

spongilla lacustris

aplysina archeri

hippospongia communis

euplectella aspergillum

aurelia aurita

physalia physalis

cyanea capillata

actinia equina

acropora cervicornis

hydra vulgaris

dugesia trigina

schistosoma mansoni

fasciola hepatica

taenia solium

taenia saginata

pseudobiceros bedfori

flagelados

ameba

radiolarios

ciliados
esporozoarios

foraminíferos